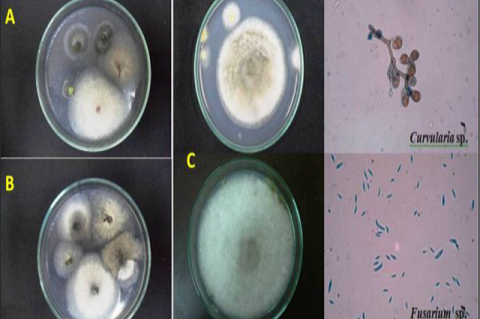
The diagram depicts the growth of endophytes from the edges of the plant leaf samples

Asian Journal of Biological and Life sciences, Vol 11, Issue 2, May-Aug, 2022
Recent Articles
Research Article
Formulation and Evaluation for Solid Lipid Microparticles of Efonidipine
Palanisamy Pethappachetty,Rajappa Margret Chandira,Meenaa Rajandhran,Dominic Antony samy
Asian J. Biol. Life Sci.,11(2):404-409 DOI: 10.5530/ajbls.2022.11.54 Published: Fri, 16-Sep-2022 Read More
Research Article
Formulation and Comparison of Cobalt and Molybdenum Glucomannan Metallocomplexes
Rajappa Margret Chandira,Palanisamy Pethappachtty,Harish Kesavan,Dominic Antony samy
Asian J. Biol. Life Sci.,11(2):410-415 DOI: 10.5530/ajbls.2022.11.55 Published: Fri, 16-Sep-2022 Read More
Research Article
A Novel Approach of Nanosponges Capsules of an Antiemetic Drug
Bendi Sri Venkateswarlu,Rajappa Margret Chandira,Palanisamy Pethappachetty,Thillai Villalan G. Tamilselvi
Asian J. Biol. Life Sci.,11(2):416-422 DOI: 10.5530/ajbls.2022.11.56 Published: Fri, 16-Sep-2022 Read More
Research Article
Formulation Development and Evaluation of Drug Loaded Microsponges of Sulindac Sodium
Palanisamy Pethappachetty,Rajappa Margret Chandira,Karthir Kumaresan,Dominic Antony samy
Asian J. Biol. Life Sci.,11(2):423-428 DOI: 10.5530/ajbls.2022.11.57 Published: Fri, 16-Sep-2022 Read More
Research Article
Analysis of Meteorological Trends of Yeldari Reservoir from Tropical Locality of Maharashtra State (India) to Evaluate Influence of changing Climate on Ichthyofauna Diversity
Maroti Govindrao Shirale,Hanumant Shahaji Jagtap
Asian J. Biol. Life Sci.,11(2):429-434 DOI: 10.5530/ajbls.2022.11.58 Published: Fri, 16-Sep-2022 Read More
Research Article
Preliminary Phytochemical, Gas Chromatography- Mass Spectroscopy Analysis and in-vitro Anticancer Activities of Macrosolen parasiticus (L.) Danser on Human Prostate Cancer Cell line (PC-3)
Keragodu Paramesh Sharath,Raja Naika
Asian J. Biol. Life Sci.,11(2):435-441 DOI: 10.5530/ajbls.2022.11.59 Published: Fri, 16-Sep-2022 Read More
Research Article
Design a Comprehensive Evaluation and Noval Approaches from Natural Source of Microspheres from Anti-hyperlipidimic Drug
Bendi Sri Venkateswarlu,Rajappa Margret Chandira,Palanisamy Pethappachetty,Naveeth Raffic
Asian J. Biol. Life Sci.,11(2):442-450 DOI: 10.5530/ajbls.2022.11.60 Published: Fri, 16-Sep-2022 Read More
Research Article
FT-IR and GC-MS Analysis of Stem Extract of Ethnomedicinal Plant: Bridelia montana (Roxb.) Willd
S Sahithya,C Krishnaveni
Asian J. Biol. Life Sci.,11(2):451-455 DOI: 10.5530/ajbls.2022.11.61 Published: Fri, 16-Sep-2022 Read More
Research Article
Molecular Analysis and Phylogenetic Relationship of Filamentous Green Algae - Pithophora roettleri (Roth) Wittrock
Nivedha D,Rehana Banu
Asian J. Biol. Life Sci.,11(2):456-460 DOI: 10.5530/ajbls.2022.11.62 Published: Fri, 16-Sep-2022 Read More
Research Article
Exploration and Studies of Wild Cymbopogon martinii (Roxb.) Wats. Growing in Devarayana Durga Hill, Karnataka
Ashwini Murthy,Vidya Jagadeeshan,Thara Saraswathi KJ
Asian J. Biol. Life Sci.,11(2):461-467 DOI: 10.5530/ajbls.2022.11.63 Published: Fri, 16-Sep-2022 Read More
Research Article
Assessment of Phytochemical, FT-IR and GC-MS Fingerprint Profiling of Marine Angiosperms Enhalus acoroides (L.f) Royle and Syringodium isoetifolium (Asch) Dandy, Gulf of Mannar Biosphere Reserve, Tamil Nadu
Murugeswaran Santhiya Selvam,Pious Soris Tresina,Jeben Benjamin,Veerabahu Ramasamy Mohan
Asian J. Biol. Life Sci.,11(2):468-475 DOI: 10.5530/ajbls.2022.11.64 Published: Fri, 16-Sep-2022 Read More
Research Article
Preliminary Phytochemical Screening and GC-MS Analysis of Ethanolic Stem Extract of the Ethnomedicinal Plant- Tinospora crispa (L.) Miers [Menispermaceae]
Akila Shree,C Krishnaveni
Asian J. Biol. Life Sci.,11(2):476-481 DOI: 10.5530/ajbls.2022.11.65 Published: Sat, 17-Sep-2022 Read More
Review Article
Antibacterial Activity of Plant-based Essential Oils against Uropathogenic Bacteria: A Systematic Review
Almirah M. Apostol,Daniel H. Bercede,Christen Amber D. Dizon,Mia Sherrie O. Ebonite,Franchesca Louise P. Guiao,Stephen Darren F. Nefulda,Rial T. Nepomuceno,Khyzyl Nicole Joy S,Andrea Pauline U. Yam
Asian J. Biol. Life Sci.,11(2):482-491 DOI: 10.5530/ajbls.2022.11.66 Published: Mon, 19-Sep-2022 Read More
Research Article
Ethnobotanical Survey on Medicinal Plants used by the Manobo Tribe of Don Marcelino, Davao Occidental, Philippines
May Ann Diaman Cabugatan,Rona Lynn Jane Ong,Liezl Sumilhig Mancao,Leonel Patoc Lumogdang
Asian J. Biol. Life Sci.,11(2):492-504 DOI: 10.5530/ajbls.2022.11.67 Published: Sat, 17-Sep-2022 Read More
Research Article
Impact on Variation in Genome Content of Wild Cymbopogon flexuosus (Nees ex Steud) Collected from Different Ecological Locations of Karnataka, India
Vidya Jagadeeshan,Suchetha Muniraju,Thara Saraswathi KJ
Asian J. Biol. Life Sci.,11(2):505-513 DOI: 10.5530/ajbls.2022.11.68 Published: Sat, 17-Sep-2022 Read More
Research Article
The Concentrations of Selected Heavy Metals in the Surface Sediments in Three Locations of Southern Philippines
Sheilane J. Gangoso,Romeo M. Del Rosario,Angelo Mark P. Walag
Asian J. Biol. Life Sci.,11(2):514-519 DOI: 10.5530/ajbls.2022.11.69 Published: Thu, 22-Sep-2022 Read More
Research Article
Histological findings of Lasia spinosa extract in Arthritic Model
Mrityunjay Kumar,Bibhuti Bhushan Kakoti,Sudarshana Borah,Kabita Mahato,Kamallochan Barman,Bhanita Das,Aditya Bora,Pallab Kalita,Innocent Sutnga
Asian J. Biol. Life Sci.,11(2):520-524 DOI: 10.5530/ajbls.2022.11.70 Published: Thu, 12-Jan-2023 Read More
Research Article
Enumeration and Identification of Surface Endophytes of Solanum lycopersicum and their Seasonal Recurrence
Lemma Abayneh,Abreham Ayele,Tesfaye Lamore,Denebo Sebaro,Vijayalakshmir Srinivasan
Asian J. Biol. Life Sci.,11(2):525-529 DOI: 10.5530/ajbls.2022.11.71 Published: Sat, 17-Sep-2022 Read More
Original Article
Acetylcholinesterase (AChE) Expression Demonstrate Differentiation of Nuclei in Rat Brain
Chouhan Anju,Bhatnagar Maheep
Asian J. Biol. Life Sci.,11(2):615-623 DOI: 10.5530/ajbls.2022.11.82 Published: Thu, 12-Jan-2023 Read More
Research Article
Effect of Lanthanum Chloride on Reproductive Efficiency of Drosophila simulans
Renuka Jyothi S,Harini BP
Asian J. Biol. Life Sci.,11(2):530-535 DOI: 10.5530/ajbls.2022.11.72 Published: Sat, 17-Sep-2022 Read More
Research Article
Physicochemical Analysis, in vitro Antioxidant and Antimicrobial Potential of Leaves of Bridelia montana (Roxb.) Willd
S Sahithya,C Krishnaveni
Asian J. Biol. Life Sci.,11(2):536-542 DOI: 10.5530/ajbls.2022.11.73 Published: Sat, 17-Sep-2022 Read More
Research Article
Factors Affecting Honey Bee Population in Western Himalaya of Uttarakhand: An Observational Study
Nagma Parveen,Kulbhushan Kumar,Rashi Miglani,Ankit Kumar,Uzma Siddiqui,Gaurav Rawat,Satpal Singh Bisht
Asian J. Biol. Life Sci.,11(2):543-553 DOI: 10.5530/ajbls.2022.11.74 Published: Thu, 22-Sep-2022 Read More
Research Article
Formulation and Evaluation of Nanosponges of an Antileprosy Drug: Topical Application
Rajappa Margret Chandira,Palanisamy Pethappachetty,Gnanasekeran Chandiran,Dominic Antony samy
Asian J. Biol. Life Sci.,11(2):554-563 DOI: 10.5530/ajbls.2022.11.75 Published: Sat, 17-Sep-2022 Read More
Research Article
Formulation and Comparison of Glucomannan Metallocomplexes Made of Cobalt and Copper
Rajappa Margret Chandira,Palanisamy Pethappachetty,Nagasubramanian Venkatasubramaniam,Dominic Antony samy
Asian J. Biol. Life Sci.,11(2):564-569 DOI: 10.5530/ajbls.2022.11.76 Published: Sat, 17-Sep-2022 Read More
Research Article












![Preliminary Phytochemical Screening and GC-MS Analysis of Ethanolic Stem Extract of the Ethnomedicinal Plant- Tinospora crispa (L.) Miers [Menispermaceae] Preliminary Phytochemical Screening and GC-MS Analysis of Ethanolic Stem Extract of the Ethnomedicinal Plant- Tinospora crispa (L.) Miers [Menispermaceae]](https://www.archives.ajbls.com/sites/default/files/styles/medium/public/AsianJBiolLifeSci-11-2-476.png?itok=VY9YUUas)